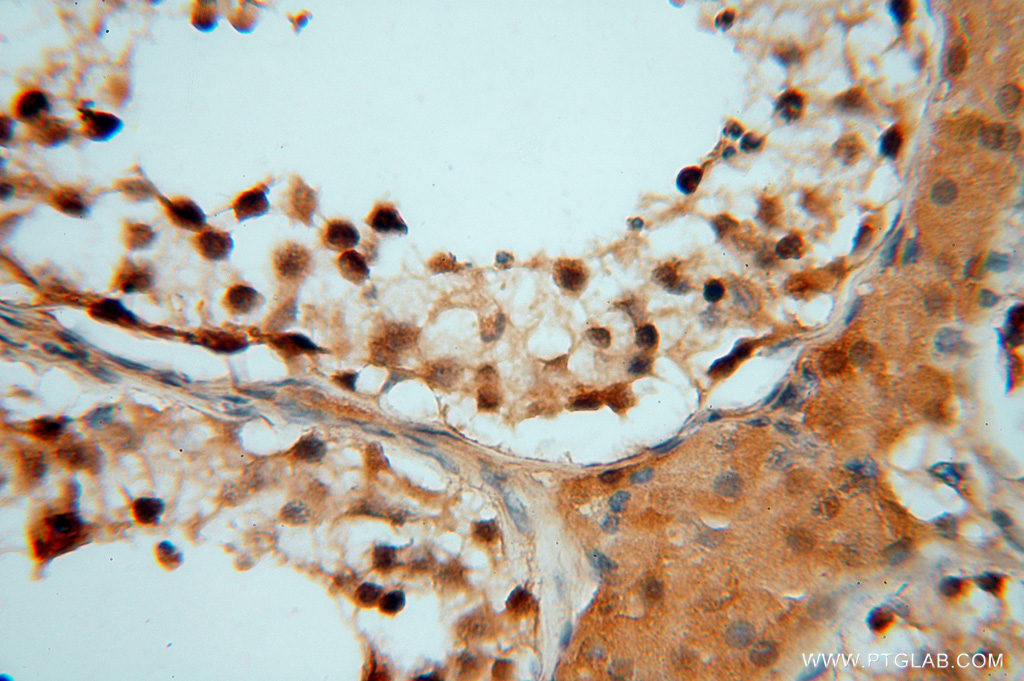

验证数据展示
经过测试的应用
| Positive WB detected in | HepG2 cells, A431 cells, HeLa cells, human liver tissue |
| Positive IP detected in | A431 cells |
| Positive IHC detected in | human testis tissue, human brain tissue, human heart tissue, human kidney tissue, human liver tissue, human ovary tissue, human skin tissue, human spleen tissue Note: suggested antigen retrieval with TE buffer pH 9.0; (*) Alternatively, antigen retrieval may be performed with citrate buffer pH 6.0 |
| Positive IF/ICC detected in | HeLa cells |
推荐稀释比
| 应用 | 推荐稀释比 |
|---|---|
| Western Blot (WB) | WB : 1:500-1:2000 |
| Immunoprecipitation (IP) | IP : 0.5-4.0 ug for 1.0-3.0 mg of total protein lysate |
| Immunohistochemistry (IHC) | IHC : 1:20-1:200 |
| Immunofluorescence (IF)/ICC | IF/ICC : 1:10-1:100 |
| It is recommended that this reagent should be titrated in each testing system to obtain optimal results. | |
| Sample-dependent, Check data in validation data gallery. | |
发表文章中的应用
| WB | See 2 publications below |
| IF | See 1 publications below |
产品信息
16152-1-AP targets HDAC2-specific in WB, IHC, IF/ICC, IP, ELISA applications and shows reactivity with human samples.
| 经测试应用 | WB, IHC, IF/ICC, IP, ELISA Application Description |
| 文献引用应用 | WB, IF |
| 经测试反应性 | human |
| 文献引用反应性 | human |
| 免疫原 |
Peptide 种属同源性预测 |
| 宿主/亚型 | Rabbit / IgG |
| 抗体类别 | Polyclonal |
| 产品类型 | Antibody |
| 全称 | histone deacetylase 2 |
| 别名 | HDAC2, RPD3, histone deacetylase 2, HD2, EC:3.5.1.98 |
| 计算分子量 | 458 aa, 52 kDa; 488 aa, 55 kDa |
| 观测分子量 | 55 kDa |
| GenBank蛋白编号 | NM_001527 |
| 基因名称 | HDAC2 |
| Gene ID (NCBI) | 3066 |
| RRID | AB_2118514 |
| 偶联类型 | Unconjugated |
| 形式 | Liquid |
| 纯化方式 | Antigen affinity purification |
| UNIPROT ID | Q92769 |
| 储存缓冲液 | PBS with 0.02% sodium azide and 50% glycerol, pH 7.3. |
| 储存条件 | Store at -20°C. Stable for one year after shipment. Aliquoting is unnecessary for -20oC storage. |
背景介绍
Histone deacetylases(HDAC) are a class of enzymes that remove the acetyl groups from the lysine residues leading to the formation of a condensed and transcriptionally silenced chromatin.Histone deacetylases act via the formation of large multiprotein complexes, and are responsible for the deacetylation of lysine residues at the N-terminal regions of core histones (H2A, H2B, H3 and H4). At least 4 classes of HDAC were identified. As a class I HDAC, HDAC2 was primarily found in the nucleus. HDAC2 forms transcriptional repressor complexes by associating with many different proteins, including YY1, a mammalian zinc-finger transcription factor. Thus, it plays an important role in transcriptional regulation, cell cycle progression and developmental events. This antibody is a rabbit polyclonal antibody raised against a peptide mapping within human HDAC2 and is specific to HDAC2. It will not cross react with other HDACs.
实验方案
| Product Specific Protocols | |
|---|---|
| IF protocol for HDAC2-specific antibody 16152-1-AP | Download protocol |
| IHC protocol for HDAC2-specific antibody 16152-1-AP | Download protocol |
| IP protocol for HDAC2-specific antibody 16152-1-AP | Download protocol |
| WB protocol for HDAC2-specific antibody 16152-1-AP | Download protocol |
| Standard Protocols | |
|---|---|
| Click here to view our Standard Protocols |
发表文章
| Species | Application | Title |
|---|---|---|
Hum Reprod Posttranslational lysine 2-hydroxyisobutyrylation of human sperm tail proteins affects motility. | ||
Chemosphere Combined exposure of lead and cadmium leads to the aggravated neurotoxicity through regulating the expression of histone deacetylase 2. | ||
Leuk Res High-expressing cystic fibrosis transmembrane conductance regulator interacts with histone deacetylase 2 to promote the development of Ph+ leukemia through the HDAC2-mediated PTEN pathway. | ||
Mol Cell Histone H3 lysine 27 crotonylation mediates gene transcriptional repression in chromatin |